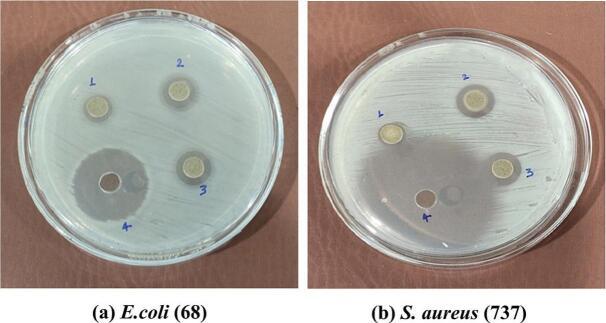
https://cdn.ncbi.nlm.nih.gov/pmc/blobs/e934/12124653/90082dd1ffc0/gr2.jpg

发酵稗米蛋白水解物的抗菌和抗蛋白酶活性。
Antibacterial and Antiprotease activities of fermented barnyard millet () protein hydrolysate.
作者信息
Kamboj Neha, Kumar Rahul, Kumar Navin, Pal Manoj, Gautam Pankaj
机构信息
Department of Microbiology, Graphic Era (Deemed to be University), 566/6, Clement Town, Dehradun 248002, UK, India.
Department of Biotechnology, Graphic Era (Deemed to be University), 566/6, Clement Town, Dehradun 248002, UK, India.
出版信息
Food Chem X. 2025 Apr 30;27:102511. doi: 10.1016/j.fochx.2025.102511. eCollection 2025 Apr.
In this study, whole protein hydrolysate (Madira, PRJ-1) of barnyard millet's seed was produced through a fermentation process using and employed as an antibacterial hydrolysate. The antibacterial properties of the protein hydrolysate were investigated against (Gram-positive) and (Gram-negative) bacterial strains, respectively, using well diffusion method. Strikingly, a significant level of inhibition was observed, revealing zones of inhibition 11 ± 1.2 mm and 12 ± 1.5 mm against Gram-positive bacteria and Gram-negative respectively. Additionally, the fermented protein hydrolysate demonstrated significant antiprotease activity, with notable percentages of trypsin inhibition. The findings indicated statistically significant ( < 0.05) inhibition of microbial growth, with minimum inhibitory concentrations (MICs) 120 μg/200 μL for and against the at pH 7.0. These results highlight the potential of whole protein hydrolysate (Madira, PRJ-1) of barnyard millet's seed as a promising bioactive hydrolysate with antimicrobial applications.
在本研究中,稗子种子的全蛋白水解物(Madira,PRJ - 1)通过发酵过程制备,并用作抗菌水解物。分别使用打孔扩散法研究了该蛋白水解物对金黄色葡萄球菌(革兰氏阳性)和大肠杆菌(革兰氏阴性)菌株的抗菌性能。令人惊讶的是,观察到显著水平的抑制作用,对革兰氏阳性菌和革兰氏阴性菌的抑菌圈分别为11±1.2毫米和12±1.5毫米。此外,发酵后的蛋白水解物表现出显著的抗蛋白酶活性,对胰蛋白酶有显著的抑制百分比。研究结果表明,在pH 7.0时,对金黄色葡萄球菌和大肠杆菌的微生物生长具有统计学显著(P < 0.05)的抑制作用,最低抑菌浓度(MICs)分别为120μg/200μL。这些结果突出了稗子种子全蛋白水解物(Madira,PRJ - 1)作为一种有前景的具有抗菌应用的生物活性水解物的潜力。